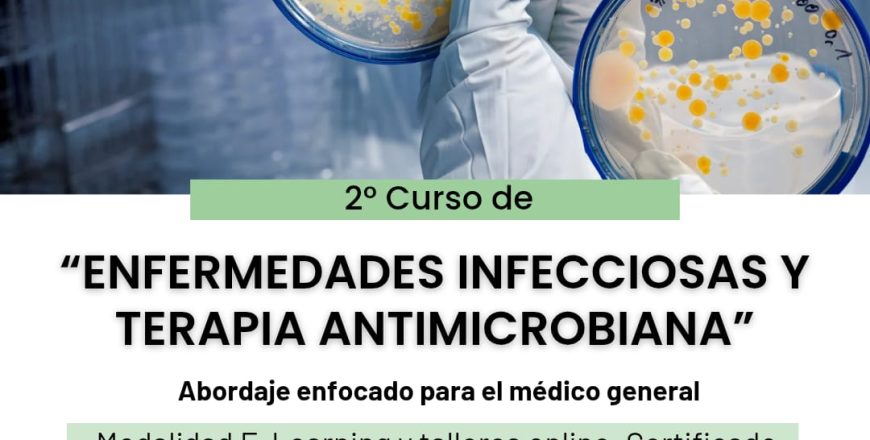
img1

- Programa
- Reseñas
SYLLABUS E INFORMACIÓN
MÓDULO I
MÓDULO II
MÓDULO III
-
19Material Complementario_Módulo III
-
20Clase 1_ Neumonía adquirida en la comunidad e Infección respiratoria superior
-
21Clase 2_ Neumonía asociada a ventilación mecánica
-
22Clase 3_ Infecciones Gastrointestinales y Abdominales
-
23Clase 4. Infecciones Gastrointestinales y Abdominales_ Hepatitis Aguda (A, B)
-
24Clase 5_ Infección de Piel y Tejidos blandos
-
25Clase 6_ Osteomielitis (aguda y crónica) artritis septica
-
26Clase 7_ Infecciones de Transmisión Sexual
MÓDULO IV
Examen Final
Por favor, inicia sesión para dejar una reseña
